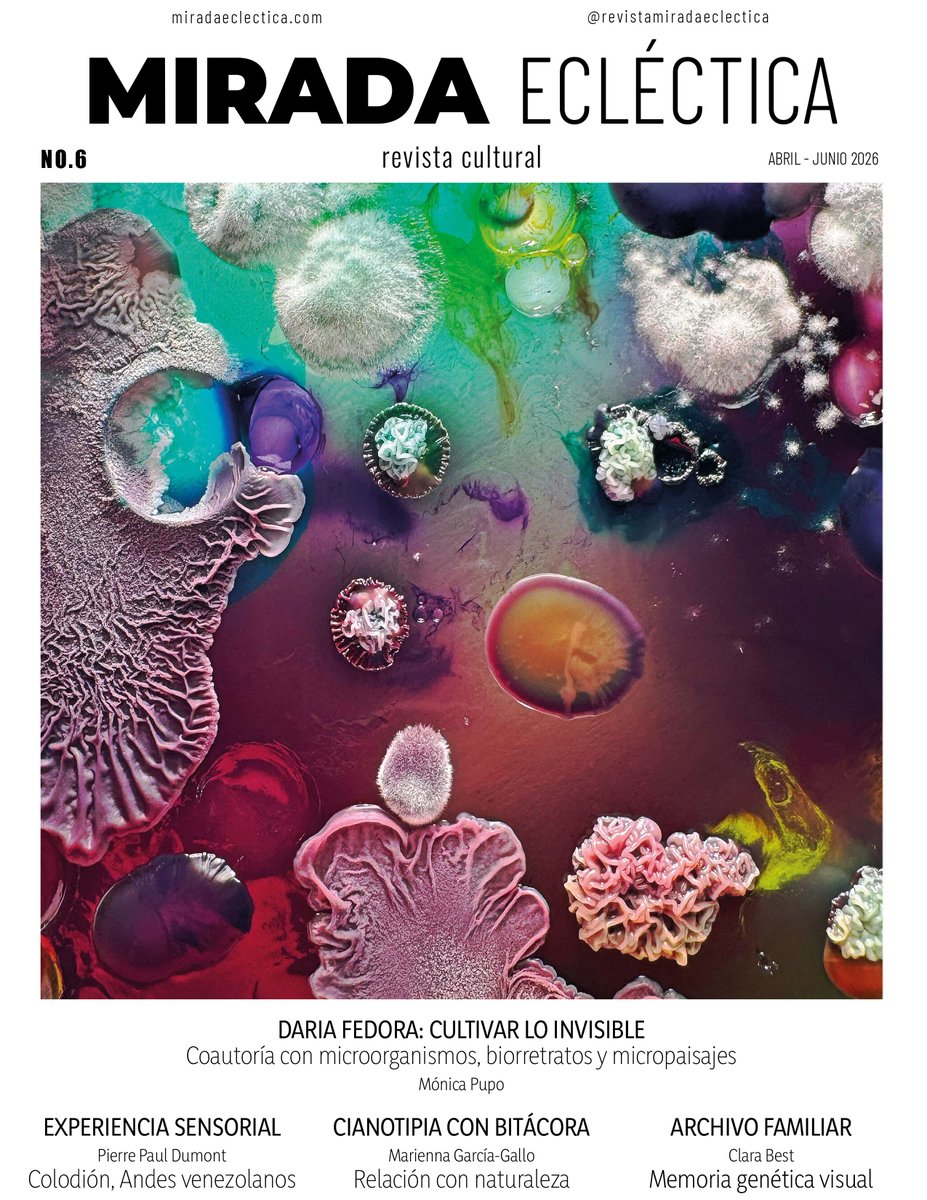
EclecticaMirada's tweet image. “La mayor parte ya se fugó antes del disparo”.
La fotografía de Pierre Paul Dumont no captura el mundo. Lo atraviesa. Cada imagen exige tiempo, materia y presencia. Artículo en la edición número 6. 👉🏻 miradaeclectica.com/revista/
#MiradaEclectica #Fotografia #AlternativePhotography

#alternativephotography hasil pencarian
As of 2011, The Great Picture (34 m wide and 9.8 m high) holds the Guinness World Record for the largest print photograph, and the camera with which it was made holds a record for being the world's largest. #alternativephotography




edgeofhumanity.com/portfolio/edge… #pinholephotography #alternativephotography #cyanotype #experimentalphotography #photographicprocess #artistresidency #conceptualphotography #timeandlight
#pinholephotography #alternativephotography #cyanotype #experimentalphotography #photographicprocess #artistresidency #conceptualphotography #timeandlight edgeofhumanity.com/portfolio/edge…
Making Wales largest cyanotype for National Creativity Day. #welshrecord #cyanotype #alternativephotography #alternativephotographicprocesses #bigcyanotype #blueprint #sunprint



edgeofhumanity.com/2026/03/31/che… #experimentalphotography #chemigrams #alternativephotography #darkroomprocess #silvergelatin #photographyprocess #analogphotography #photographicprint #resisttechnique #caffenol #photographyseries #contemporaryphotography #fineartphotography
edgeofhumanity.com
Chemigrams & The Experimental Darkroom Process
Photographer Hannah Schneider is the Edge of Humanity Magazine contributor of these images. From the project ‘Chemigrams’. To see Hannah ’s body of work, click on any photograph. Series 1 …
🌿 Want to learn anthotypes or ready to dive deeper? -> Start with Anthotypes – the how-to guide -> Want pigments + recipes? Explore Anthotype Emulsions Vols 1–3 👉 alternativephotography.com/anthotype-book… #Anthotype #AlternativePhotography #AltProcess #PlantBasedArt #CameraLessPhotography
edgeofhumanity.com/2025/04/06/ros… #alternativephotography #darkroomexperiments #environmentalphotography #rosignanosolvay #spiaggebianche #chemicallandscapes #sodaashprints #experimentalprints #toxicbeauty #photographyandprocess #landscapealteration #industrialpollution
edgeofhumanity.com
Rosignano Solvay A Dialogue Between Process & Place
Photographer Kari Varner is the Edge of Humanity Magazine contributor of this photo essay. From the project ‘Rosignano Solvay’. To see Kari ’s body of work, click on any photograph. …
edgeofhumanity.com/2026/01/29/mec… #pinholephotography #alternativephotography #cyanotype #experimentalphotography #photographicprocess #artistresidency #conceptualphotography #timeandlight
edgeofhumanity.com
Mechanics & The Physical Act Of Image Making
Photographer Fabrice Lassort is the Edge of Humanity Magazine contributor of this photo essay. From the project ‘Mechanics’. To see Fabrice ’s body of work, click on any photograph. …
edgeofhumanity.com/portfolio/edge… #experimentalphotography #chemigrams #alternativephotography #darkroomprocess #silvergelatin #photographyprocess #analogphotography #photographicprint #resisttechnique #caffenol #photographyseries #visualexperimentation #artphotography
Pleased to hear that our exhibition @TheHiveJQ is being extended until 10th February. Open Tuesday-Friday 10am -3pm on Vittoria st. #alternativephotography #altprocess
BEYOND SILVER at @TheHiveJQ . Exhibition continues until 03 Feb. More information and photos on our website: londonaltphoto.com



“La mayor parte ya se fugó antes del disparo”. La fotografía de Pierre Paul Dumont no captura el mundo. Lo atraviesa. Cada imagen exige tiempo, materia y presencia. Artículo en la edición número 6. 👉🏻 miradaeclectica.com/revista/ #MiradaEclectica #Fotografia #AlternativePhotography

edgeofhumanity.com/portfolio/edge… #experimentalphotography #chemigrams #alternativephotography #darkroomprocess #silvergelatin #photographyprocess #analogphotography #photographicprint #resisttechnique #caffenol #photographyseries #visualexperimentation #artphotography
edgeofhumanity.com/2026/03/31/che… #experimentalphotography #chemigrams #alternativephotography #darkroomprocess #silvergelatin #photographyprocess #analogphotography #photographicprint #resisttechnique #caffenol #photographyseries #contemporaryphotography #fineartphotography
edgeofhumanity.com
Chemigrams & The Experimental Darkroom Process
Photographer Hannah Schneider is the Edge of Humanity Magazine contributor of these images. From the project ‘Chemigrams’. To see Hannah ’s body of work, click on any photograph. Series 1 …
#alternativephotography #altphotography #analogphotography #experimentalphotography #portraitphotography #darkaesthetic #moodygrams #fineartphotography #filmphotography #artisticphotography

#alternativebrewing #alternativewedding #alternativephotography #alternativebride #nativeamericanpride

Join us to discover more images and videos celebrating Native American culture 💘💘 Feel free to share your favorite snapshots and clips for us to feature. . . . DM for removal. credit : genebraverock . . . #alternativebrewing #alternativewedding #alternativephotography .
instagram.com/p/DLXLzivSBx9/… #FilmSwap #DoubleExposure #AlternativePhotography #AnalogPhotography #filmphotography
instagram.com
If Sg (@international.film.swap.group) • Instagram photo
If Sg (@international.film.swap.group) • Instagram photo
- A4 flying Dragon - Mixed media #acrylic #ink #alternativephotography #mixedmedia #nature #environment #foundobjects #dragon #art #arton #sudbury #suffolk #papertwists

This is DIY photography at its most elemental. Ready to try? Full guide here 👉 diyphotography.net/how-to-make-cy… #DIYPhotography #Cyanotypes #AlternativePhotography #PhotographyTips #SunPrints #HandmadePhotos #CreativePhotography
diyphotography.net
How to Make Cyanotypes: A Step-by-Step Guide to Sun-Printed Magic
The process of cyanotypes is one of the oldest methods of making photographic prints. The strikingly beautiful blue colours set cyanotypes apart, and they make...
#cyanotype #sunprint #alternativephotography #watercolour #deer #environment #nature #art #arton #sudbury #suffolk #papertwists

Cyanotype Misadventure #cyanotype #blueprint #alternativephotography #mixedmedia #fox #foxspirit #pagan #ancientwoods #nature #environment #arton #sudbury #suffolk #apertwists

Cyanotype and Ink #cyanotype #alternativephotography #nature #environment #woods #woodlandspirit #ancientwoods #art #sudbury #Suffolk #papertwists

In PRINT now! photoed.ca/current-issue - or- Digital Replica: issuu.com/photoedmagazin… 🇳🇿 Rosemary Horn • Reimagining the Brook Valley: The making and remaking of land photogirl.co.nz @photogirl168 #AlternativePhotography



Something went wrong.
Something went wrong.
United States Trends
- 1. Lemon N/A
- 2. McVay N/A
- 3. #Kehlani N/A
- 4. Rams N/A
- 5. Stafford N/A
- 6. Ty Simpson N/A
- 7. Jokic N/A
- 8. Jaden McDaniels N/A
- 9. #SECAwards N/A
- 10. Bain N/A
- 11. Steelers N/A
- 12. Jets N/A
- 13. Wack N/A
- 14. #zzzSpecialProgram N/A
- 15. DeepSeek V4 N/A
- 16. Enid N/A
- 17. Nuggets N/A
- 18. Eagles N/A
- 19. Beane N/A
- 20. McCoy N/A













































